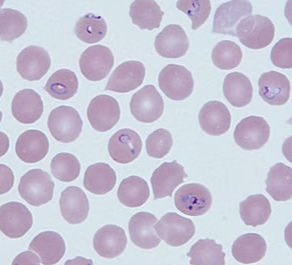

Onlangs is de USTAR sneltest voor malaria op de Europese markt geïntroduceerd. Gezien de impact van malaria in endemische gebieden, hebben we deze test vergeleken met een andere, gangbare moleculaire sneltest voor malaria screening: Alethia. Lees hieronder de resultaten van het onderzoek.
Malaria
Malaria is wereldwijd één van de belangrijkste infectieziekten en veroorzaakt veel sterfte in endemische gebieden. In niet-endemische landen, zoals Nederland, kan het ook gevaarlijk zijn voor terugkerende reizigers zonder immuniteit. Door de beperkte ervaring met malaria in niet-endemische regio’s, is snelle en gevoelige diagnostiek belangrijk om fatale gevolgen te voorkomen.
Beide testen betrouwbaar
Ons onderzoek vergelijkt twee moleculaire sneltesten: USTAR en Alethia. Beide zijn snel en gevoelig, maar verschillen in workflow. Voor allebei geldt dat binnen 2,2 uur na aanvraag bekend is wie zeker geen malaria heeft. Dit betekent niet alleen een snellere uitslag dan gespecialiseerd onderzoek op centrale locatie, maar ook minder oproepen voor analisten buiten werktijden.
Meer impact USTAR
Beide testen helpen malaria snel uit te sluiten, waardoor patiëntenzorg verbetert en laboratoria efficiënter werken. Maar de USTAR-test biedt daarnaast als voordeel dat de uitslag automatisch gerapporteerd kan worden, wat snellere klinische besluitvorming mogelijk maakt. Bovendien vereist deze sneltest minder handelingen vanuit de analist, wat een extra besparing oplevert.
Lees hier het het volledige artikel.
Samenwerking
Dit onderzoek is een samenwerking tussen Rijnstate, Dicoon, Makerere University te Kampala en ANBI-stichting Global Health Initiative. Als verbindende factor tussen Nederland en Oeganda speelt Global Health Initiative een cruciale rol in het overbruggen van de kloof tussen onderzoek en klinische toepassing in zowel endemische als niet-endemische gebieden.
Volgende stap
De volgende stap van deze samenwerking is het testen van de USTAR-test in Oeganda, waar malaria een grote impact heeft. Hierbij zal ook de Technische Universiteit Eindhoven betrokken zijn. Het onderzoek in Oeganda zal waardevolle inzichten bieden in de toepasbaarheid van de test in endemische gebieden en mogelijk bijdragen aan verbeterde zorg.
Lees hier het volledige artikel